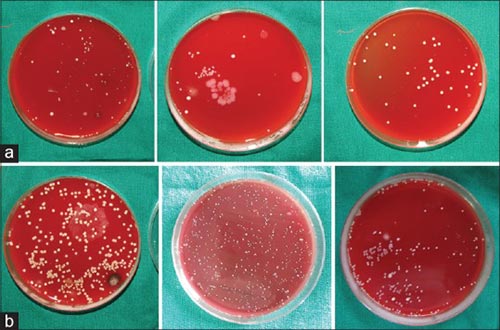

電話:13570151199
傳真:020-39972520
郵箱:hanyan@hanyancarbon.com
地址:廣東省廣州市番禺區(qū)東環(huán)街番禺大道北555號天安總部中心30號樓6層
活性炭牙刷的抗菌實(shí)驗(yàn),本研究的目的是評估活性炭制成的牙刷刷毛與常用牙刷中的非炭鬃毛相比的細(xì)菌污染和抗菌效果。找50個(gè)參與者,在使用活性炭牙刷時(shí)給予標(biāo)準(zhǔn)刷牙說明,并要求在使用1周后將使用過的刷子歸還。在1周的清洗期后,然后向參與者提供非活性炭牙刷并給予兩組相似的刷牙說明,并指示在使用一周后將刷子返回。將用過的牙刷的刷毛切片并置于5ml鹽水中,并將0.1ml接種在血瓊脂平板上,然后將其置于氣體包裝罐中進(jìn)行厭氧培養(yǎng)。孵育48小時(shí)后測量菌落形成單位(CFU)。為了評估木炭刷毛的抗菌功效,在孵育24小時(shí)后評估活性炭與非炭的抑制區(qū)。

圖1:(a)活性炭牙刷。(b)非炭牙刷。切下刷毛并在分開的無菌培養(yǎng)皿上收集。

圖2:使用無菌棉簽將溶液涂抹在瓊脂平板上。

圖3:(a)然后將瓊脂平板置于氣體包裝罐中進(jìn)行厭氧培養(yǎng)。(b)然后將氣體包裝罐置于培養(yǎng)箱中48小時(shí)。
圖4:(a)厭氧培養(yǎng)48小時(shí)后活性炭刷毛的菌落形成單位。(b)厭氧培養(yǎng)48小時(shí)后的非炭鬃毛菌落形成單位。

圖5:(A)與木炭刷毛有關(guān)的10毫米抑制區(qū)。(B)發(fā)現(xiàn)與非炭鬃相關(guān)的3mm抑制區(qū)。
從參與者那里收集了總共100把牙刷50個(gè)活性炭和50個(gè)非活性炭。在100個(gè)瓊脂平板中,所有平板都被認(rèn)為具有微生物菌落并包括在分析中。孵育24小時(shí)后血瓊脂平板未見生長,然而,在孵育48小時(shí)后觀察到菌落。與使用過的活性炭牙刷相比,在使用過的非炭刷的瓊脂平板上觀察到更高的CFU計(jì)數(shù)。比較了兩種類型刷毛之間的CFU數(shù)量。非炭鬃毛的平均CFU幾乎是活性炭刷毛的兩倍。因此,兩種產(chǎn)品之間存在顯著差異用于測試活性炭牙刷的抗菌功效的結(jié)果發(fā)現(xiàn),與非炭牙刷相比,活性炭牙刷的抑制區(qū)域?yàn)?0mm,發(fā)現(xiàn)為3mm。證明活性炭牙刷具有抗菌功效。
活性炭本身是一種吸附劑,具有吸附性,工業(yè)上可以用作凈水材料,廢氣處理材料等。為了減少用過的牙刷的污染,在牙刷刷毛上添加抗菌物質(zhì)并不是一種新現(xiàn)象,然而使用活性炭作為牙刷抗菌材料是最近比較新潮的。其實(shí)活性炭的用處還有很多,我們還有更多的領(lǐng)域需要探索。如果您有什么新奇的想法,可以聯(lián)系我們一起探索活性炭的奧秘。
文章標(biāo)簽:椰殼活性炭,果殼活性炭,煤質(zhì)活性炭,木質(zhì)活性炭,蜂窩活性炭,凈水活性炭.本文鏈接:http://www.arogyaherbs.com/hangye/hy651.html
查看更多分類請點(diǎn)擊:公司資訊 行業(yè)新聞 媒體報(bào)導(dǎo) 百科知識(shí)
推薦資訊
- 2025-11-27超細(xì)活性炭5000目粉末活性炭
- 2025-11-26活性炭在硫化橡膠襯套中的應(yīng)用
- 2025-11-19活性炭吸附重晶石混合物中的銅和鋅
- 2025-11-10活性炭去除PFAS
- 2025-11-03防一氧化碳霍加拉特劑
- 2025-11-03防汞蒸汽專用炭防放射性碘專用炭
- 2025-11-03防酸專用炭與防氨專用炭
- 2025-11-03防護(hù)服專用炭及全防炭的介紹應(yīng)用
- 2025-10-21活性炭從堿性甘氨酸溶液中吸附鉑
- 2025-10-10活性炭金屬改性對氫的吸附
- 2025-09-29活性炭吸附有機(jī)微污染物
- 2025-09-17活性炭去除對羥基苯甲醚
